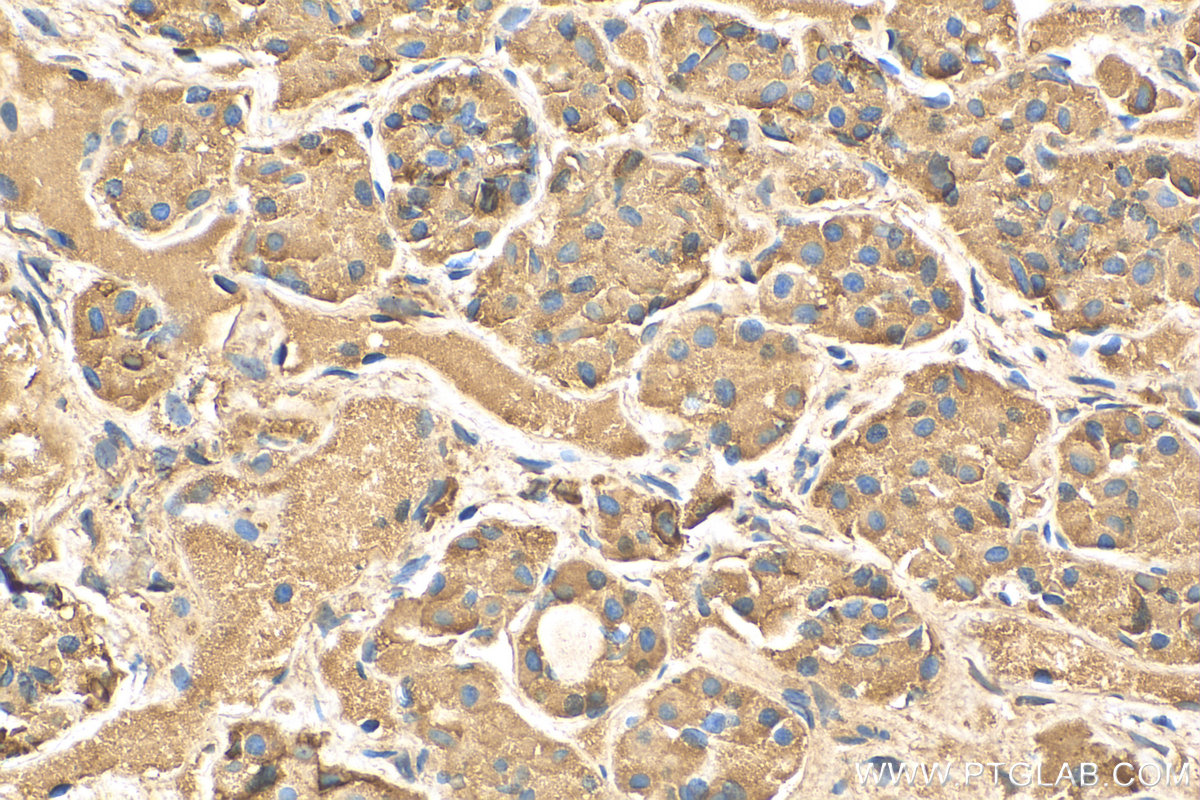

验证数据展示
经过测试的应用
| Positive IHC detected in | human pituitary tissue, rat testis tissue, mouse testis tissue Note: suggested antigen retrieval with TE buffer pH 9.0; (*) Alternatively, antigen retrieval may be performed with citrate buffer pH 6.0 |
| Positive IF/ICC detected in | COS-7 cells |
推荐稀释比
| 应用 | 推荐稀释比 |
|---|---|
| Immunohistochemistry (IHC) | IHC : 1:400-1:1600 |
| Immunofluorescence (IF)/ICC | IF/ICC : 1:200-1:800 |
| It is recommended that this reagent should be titrated in each testing system to obtain optimal results. | |
| Sample-dependent, Check data in validation data gallery. | |
产品信息
16525-1-AP targets Prolactin in WB, IHC, IF/ICC, ELISA applications and shows reactivity with human, mouse, rat samples.
| 经测试应用 | IHC, IF/ICC, ELISA Application Description |
| 文献引用应用 | WB, IHC, IF |
| 经测试反应性 | human, mouse, rat |
| 文献引用反应性 | human |
| 免疫原 |
CatNo: Ag9764 Product name: Recombinant human PRL protein Source: e coli.-derived, PGEX-4T Tag: GST Domain: 1-227 aa of BC015850 Sequence: MNIKGSPWKGSLLLLLVSNLLLCQSVAPLPICPGGAARCQVTLRDLFDRAVVLSHYIHNLSSEMFSEFDKRYTHGRGFITKAINSCHTSSLATPEDKEQAQQMNQKDFLSLIVSILRSWNEPLYHLVTEVRGMQEAPEAILSKAVEIEEQTKRLLEGMELIVSQVHPETKENEIYPVWSGLPSLQMADEESRLSAYYNLLHCLRRDSHKIDNYLKLLKCRIIHNNNC 种属同源性预测 |
| 宿主/亚型 | Rabbit / IgG |
| 抗体类别 | Polyclonal |
| 产品类型 | Antibody |
| 全称 | prolactin |
| 别名 | PRL |
| 计算分子量 | 227 aa, 26 kDa |
| GenBank蛋白编号 | BC015850 |
| 基因名称 | Prolactin/PRL |
| Gene ID (NCBI) | 5617 |
| RRID | AB_2935439 |
| 偶联类型 | Unconjugated |
| 形式 | Liquid |
| 纯化方式 | Antigen affinity purification |
| UNIPROT ID | P01236 |
| 储存缓冲液 | PBS with 0.02% sodium azide and 50% glycerol, pH 7.3. |
| 储存条件 | Store at -20°C. Stable for one year after shipment. Aliquoting is unnecessary for -20oC storage. |
背景介绍
Prolactin is also named as PRL and belongs to the somatotropin/prolactin family. The proteins encoded by PRL are secreted into the cell surroundings. And they are abundantly expressed in pituitary gland, adenohypophysis, decidua and testis. Indeed, chemically, prolactin appears in a multiplicity of posttranslational forms ranging from size variants to chemical modifications such as phosphorylation or glycosylation. It is not only synthesized in the pituitary gland, as originally described, but also within the central nervous system, the immune system, the uterus and its associated tissues of conception, and even the mammary gland itself (PMID: 11015620). Prolactin acts primarily on the mammary gland by promoting lactation (PMID: 30546056). The major form of prolactin found in the pituitary gland is 23 kDa, variants of prolactin have been characterized in many mammals, including humans. Of the cleaved forms that have been characterized, 14 kDa, 16 kDa, and 22 kDa prolactin variants have been most widely studied (PMID: 7937959) (PMID: 8425495).
实验方案
| Product Specific Protocols | |
|---|---|
| IF protocol for Prolactin antibody 16525-1-AP | Download protocol |
| IHC protocol for Prolactin antibody 16525-1-AP | Download protocol |
| Standard Protocols | |
|---|---|
| Click here to view our Standard Protocols |
发表文章
| Species | Application | Title |
|---|---|---|
Transl Cancer Res Prolactin (PRL), placenta growth factor (PIGF) and nerve growth factor receptor (NGFR) as biomarkers for early diagnosis and prognosis in patients with esophageal squamous cell carcinoma (ESCC) | ||
Mol Med PYK2 promotes cell proliferation and epithelial-mesenchymal transition in endometriosis by phosphorylating Snail1 | ||
Mol Cell Endocrinol Embryo-derived human chorionic gonadotropin promotes human decidualization through activating epithelial prostaglandin F2α secretion | ||
Biol Reprod Impaired Decidualization and Angiogenesis in Eutopic Endometrium of Endometriosis: Insights from In Vitro Models | ||
J Obstet Gynaecol Abnormal expression of Hippo-YAP1 signalling pathway and progesterone resistance mechanism in endometrial polyps |